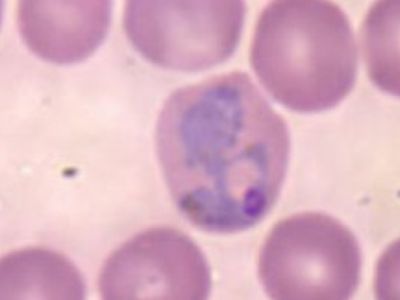
В Литве появилась малярия - Наука и здоровье

Аккумуляторные станции в Литве: появятся ли они и в Висагинасе? (видео)
Мы поинтересовались у директора Игналинской АЭС - Линаса Баужиса принимает ли “Altra” участие в таких проектах
У жителя Каунасского района Литвы, который в начале августа побывал в Гане, обнаружена малярия, сообщил Каунасский центр общественного здоровья.

В литовский портовый город Клайпеда сегодня, 29 августа, прибыл первый танкер с нефтью из Венесуэлы, которая была отгружена и будет ...

«Республике» стало известно, что нынешней весной некими силами предпринимались провокации и в Висагинасе.

Бедствующие литовские пенсионеры ищут защиты не у политиков, а в судах: пожилые люди просят взыскать с чиновников сокращенную пенсию и ...

Литовские компании «Восточные распределительные сети» (RST) и «Западные распределительные сети» (VST) не рассматривают возможность введения абонентной платы — так называемого ...

C 20 по 26 августа в Литве в дорожно-транспортных происшествиях погибли 8 человек.

В 2010 году самоуправлению латвийской столицы не хватит на выплату социальных пособий 1,08 млн

Эффективное управление госимуществом принесет Литве миллионные доходы.

Британские исследователи установили, что наиболее красивыми женщины становятся после 30 лет.


Самый дорогой в модельной линейке Bentley — седан Muslanne — распродан в России до конца 2011 года.

Все знают, что носить каблуки вредно для здоровья — это провоцирует плоскостопие, нарушает осанку, смещает центр тяжести, деформирует мышцы.

Интервью с руководителем Координационного совета российских соотечественников, проживающих в Литве, и членом Всемирного координационного совета А


По данным на 26 августа 1 сентября в шесть городских школ впервые придут 197 детей.


Российский специалист Сергей Юран прокомментировал вылет «Зенита» из Лиги чемпионов.
Блокированным под землей 33 шахтерам в Чили рекомендовали не толстеть, чтобы поместиться в тоннель, который планируется пробурить для их спасения.

Первый и единственный концерт ирландской рок-группы U2 в Москве, состоявшийся 25 августа, собрал меньше зрителей, чем ожидалось.

Министр образования и науки Тынис Лукас заявил о том, что под видом движения, организуемого родителями учеников русских школ, может скрываться ...

Быстро летит время — ТЦ «Domino» уже два года служит верой и правдой висагинцам и гостям города.


Для причисления Матери Терезы к лику святых специальной комиссии не хватает подтверждения случаев совершенных ею чудес, сообщает Earthtimes.

Правительство Литвы вчера, 25 августа, прокомментировало журналистам полученные письма из «Газпрома», которые сами члены литовского кабинета министров оценивают как «угрозу».

В столице Литвы Вильнюсе сегодня, 26 августа, завершается ежегодный съезд глав дипломатических представительств страны.


Криминальные происшествия за период с 20 по 23 августа.


Народному артисту СССР, знаменитому режиссеру Георгию Данелия сегодня исполняется 80 лет.

Высший представитель Европейского Союза по внешней политике Кэтрин Эштон проводит набор послов на должности представителей ЕС.